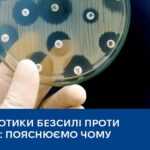
Антибіотики безсилі проти вірусів: пояснюємо чому

Отруєння грибами: як вберегтися та що робити у разі появи симптомів
Пік грибного сезону традиційно припадає на осінь, а разом із ним зростає кількість отруєнь. Головні причини отруєнь грибами: помилкове визначення грибів (найпоширеніша причина), наприклад, бліду поганку часто плутають із печерицею або підберезником, а помилкові опеньки — зі справжніми; недотримання правил збирання, Читати далі